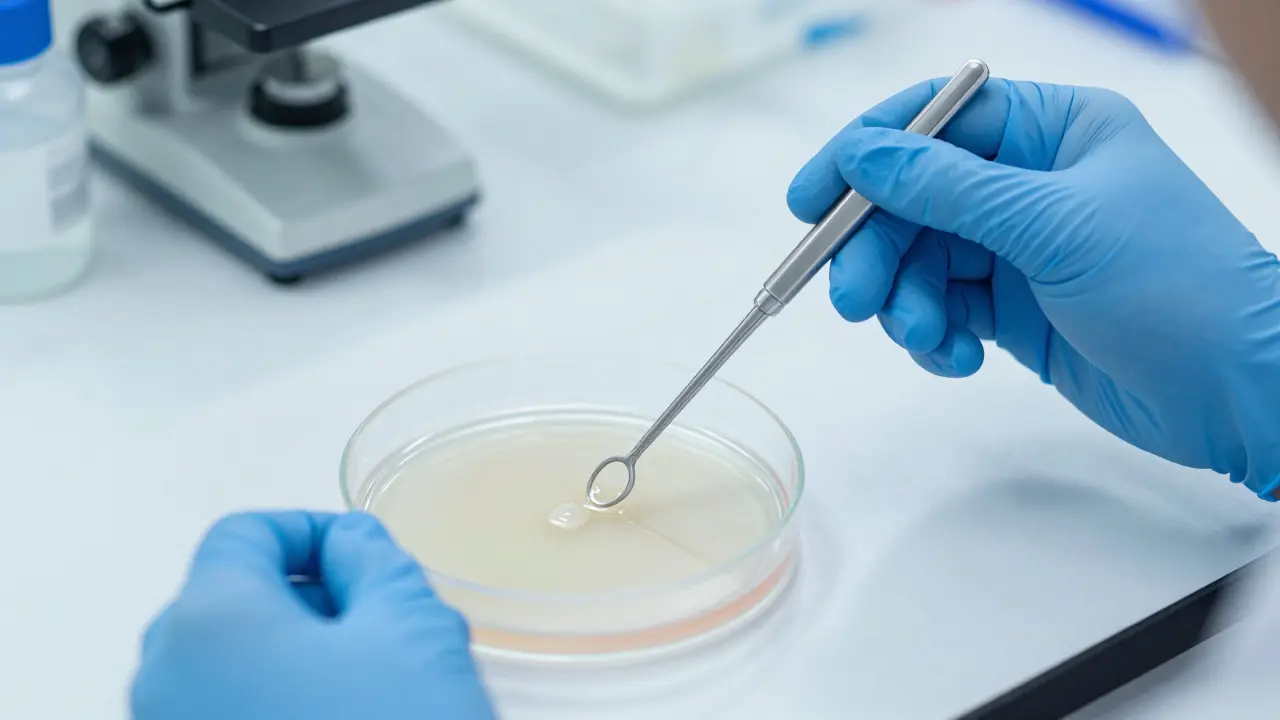
Mikrobiologické vyšetření: Jak funguje a co znamenají výsledky?

Simulátor Interpretace Mikrobiologického Nálezu
Rychlý přehled: Co potřebujete vědět
- Účel: Identifikace konkrétního mikroorganismu způsobujícího nemoc.
- Průběh: Odběr vzorku → kultivace (náles) → identifikace → citlivostní test.
- Hlavní cíl: Výběr nejúčinnějšího antibiotika nebo antifungika.
- Čas: Výsledky trvají od 2 do 7 dní v závislosti na rychlosti růstu mikroba.
Co přesně je mikrobiologické vyšetření?
Když mluvíme o mikrobiologické vyšetření is diagnostickým postupem, který slouží k detekci mikroorganismů v tělesných tekutinách nebo tkáních, myslíme v podstatě detektivní práci v mikroskopickém měřítku. Nejde jen o to zjistit, že v těle něco "je", ale přesně určit, zda jde o bakterii, plísni nebo virus.
Většina těchto testů spadá pod obor bakteriologie, která se specializuje na studium bakterií. Laboratoř nehledá jen přítomnost mikroba, ale snaží se zjistit jeho množství a chování. Pokud například trpíte chronickým zánětem močových cest, lékař potřebuje vědět, zda za problém stojí běžná Escherichia coli, nebo zda jde o něco vzácnějšího, co vyžaduje specifickou léčbu.
Jak probíhá cesta vzorku z těla do výsledků?
Proces není okamžitý, protože mikroby musí růst. Představte si to jako pěstování malého "zahrady" v Petriho misce. Zde je přesný postup, kterým váš vzorek prochází:
- Odběr materiálu: Podle typu infekce se bere krev, moč, hlen z plic, hnis z rány nebo stěr z krku. Důležité je, aby vzorek nebyl kontaminován (např. aby se do moči nedostaly bakterie z kůže).
- Primární osev: Laborant nanese vzorek na kultivační médium, což je v podstatě "výživnývypálený gel" (agar), který obsahuje vše, co bakterie potřebují k růstu.
- Inkubace: Misky se umístí do inkubátoru s přesně nastavenou teplotou (často 37 °C, tedy teplota lidského těla) a vlhkostí. Zde se čeká, až vznikne viditelný kolonie bakterí.
- Identifikace: Jakmile bakterie vyrostou, laborant je zkoumá pod mikroskopem a provádí biochemické testy. Zjistí se např. barva kolonií nebo to, zda bakterie dokáže rozložit určitý cukr.
- Citlivostní test (Antibiogram): Toto je nejdůležitější část. Na kultivované bakterie se přiloží disky s různými antibiotiky. Kolem disků, které bakterii zabijí, vznikne čistá zóna. Tak lékař pozná, který lék funguje nejlépe.

Kdy je toto vyšetření nezbytné a co se z něj hledá?
Ne každé nachlize století vyžaduje mikrobiologii. Pokud máte lehce rýmu, je to zbytečné. Ale existují situace, kdy je to naprosto kritické. Podívejme se na konkrétní příklady:
- Krevní kultury: Při podezření na sepsi (systémový zánět krve) je toto vyšetření otázkou života a smrti. Zde se hledá přítomnost bakterií v krvi, kde by normálně být neměly.
- Močové sedimenty a kultivace: Pomáhá odlišit běžné podráždění od bakteriálního zánětu ledvin (pyelonefritidy).
- Stěry z ran: Pokud rána nehojí nebo hnisá, hledá se např. Staphylococcus aureus, který může být odolný vůči běžným lékům.
- Sputum (vykašlačky): Klíčové při diagnostice pneumonie, aby se určilo, zda je příčina bakteriální (např. pneumokoky), nebo virová.
| Typ mikroba | Rychlost růstu | Typicky hledané entity | Metoda detekce |
|---|---|---|---|
| Bakterie | Rychle (24-72h) | Stafylokoky, Streptokoky | Kultivace na agaru |
| Kvasinky/Plísně | Pomaleji (3-7 dní) | Candida, Aspergillus | Sablevsky agar |
| Mykobakterie | Velmi pomalu (týdny) | TBC (Tuberkuloza) | Speciální tekutá média |
Čtení výsledků: Co znamenají ty odborné termíny?
Když dostanete do ruky papír z laboratoře, může se zdát, že je napsaný v jiném jazyce. Pojďme si osvětlit ty nejčastější pojmy, které s vámi lékař pravděpodobně prodiskutuje.
Pokud vidíte výraz "Negativní“ nebo "Žádný růst“, je to obecně dobrá zpráva. Znamená to, že v inkubovaném vzorku nevyrostly žádné patogeny. Nicméně, pokud je v reportu napsáno "Kvalitativně negativní, ale kvantitativně přítomno...“, může jít o kolonizaci, což znamená, že bakterie jsou přítomny, ale nezpůsobují aktivní nemoc.
U antibiogramu uvidíte zkratky jako S (Sensitive), I (Intermediate) a R (Resistant). Antibiotická citlivost označená jako S znamená, že lék bakterii spolehlivě zničí. R znamená, že bakterie se proti němu imunizovala a lék by byl v podstatě k ničemu. Právně proto je toto vyšetření tak cenné - brání vám v užívání neúčinných léků.

Kritické chyby při odběru: Proč se může stát, že výsledek lže?
Mikrobiologie je extrémně citlivá disciplína. Stačí jedna malá chyba a výsledek bude zavádějící. Nejčastěji se setkáváme s tzv. kontaminací. Představte si, že si před odběrem moči pořádně neumyjete ruce nebo nepoužijete sterilní nádobku. Do vzorku se dostanou bakterie z povrchu kůže, které s vaší nemocí nemají nic společného, ale v laboratoři vyrostou. Výsledek pak ukáže přítomnost bakterií, i když vaše močové cesty jsou čisté.
Další problém je předčasné užívání antibiotik. Pokud začnete brát lék dříve, než odejdete na odběr, bakterie v těle mohou být potlačené, ale ne zcela zničeny. V laboratoři pak "nespustí" (nevyrostou), přestože infekce stále probíhá. To vede k falešně negativnímu výsledku, což může způsobit, že lékař předpokládá, že jste zdravý, zatímco nemoc jen krátce usnula.
Moderní alternativy: Je kultivace stále nejlepší cestou?
Tradiční kultivace je zlatým standardem, ale má jednu velkou nevýhodu: čas. Dny čekání mohou být pro pacienty s těžkou infekcí kritické. Proto se dnes stále více využívá PCR testace (Polymerase Chain Reaction). PCR nečeká, až bakterie vyroste, ale hledá její specifický genetický kód (DNA).
PCR je bleskový - výsledky mohou být hotové za pár hodin. Má však své limity. Zatímco PCR vám řekne, že v těle je DNA konkrétní bakterie, neřekne vám, zda je tato bakterie stále živá a aktivní, ani jaká je citlivost k antibiotikům. Proto se v praxi často kombinuje: PCR pro rychlou orientaci a kultivace pro přesný plán léčby.
Jak dlouho trvá mikrobiologické vyšetření?
Standardní bakteriologické kultivace trvají obvykle 2 až 5 dní. Tento čas je dán biologickým tempem růstu bakterií. Pokud jsou však vyšetřovány plísně nebo mykobakterie (např. u TBC), může proces trvat několik týdnů. Moderní molekulární metody jako PCR jsou mnohem rychlejší a mohou poskytnout výsledek během několika hodin.
Je nutné být před vyšetřením hladový?
Na rozdíl od vyšetření cukru nebo cholesterolu, mikrobiologické vyšetření většinou nevyžaduje hladovění. Důležitější je však dodržení hygienických pravidel při odběru vzorku a v ideálním případě nepoužívání antibiotik alespoň 3 až 7 dní před odběrem, aby nedošlo k potlačení růstu mikroorganismů v laboratoři.
Co dělat, když je můj nález "negativní“, ale stále mám symptomy?
Negativní nález může znamenat několik věcí: buď infekce není bakteriální (může jít o virus, na který kultivace nefunguje), buď jste užili antibiotika před odběrem, nebo byl vzorek odebrán z místa, kde patogen nebyl přítomen. V takovém případě je vhodné konzultovat s lékařem opakovaný odběr nebo změnu metody na PCR.
Je rozdíl mezi stěrem a kultivací?
Ano. Stěr je samotný proces odebrání materiálu (např. pomoci vatové tyčinky z krku nebo rány). Kultivace je následný laboratorní proces, kdy se tento stěr zasadí do živného prostředí, aby se mikroby rozmnožily a mohly být identifikovány. Stěr je tedy "zber", kultivace je "vývoj".
Proč se kontroluje citlivost na více typů antibiotik?
Bakterie vyvíjejí rezistenci. To znamená, že některé kmeny jsou přirozeně imunní vůči některým lékům. Testováním širokého spektra antibiotik laboratoř najde ten nejúčinnější lék s nejmenším amountem vedlejších účinků pro pacienta a zabraňuje neúčinné léčbě, která by jen prodlužovala nemoc.
Další kroky a řešení problémů
Pokud jste právě dostali výsledky svého vyšetření, nejdůležitější je neinterpretovat je samostatně, ale v kontextu vašich příznaků. Pokud jste v situaci, kdy výsledky přišly jako negativní, ale cítíte se stále špatně, zvažte následující kroky:
- Prověřte si časovou linii: Vzpomněte si, zda jste užili nějaký antiseptikum nebo antibiotikum krátce před odběrem.
- Požádejte o jinou metodu: Zeptejte se lékaře, zda by nebyla vhodnější PCR metoda, která detekuje DNA patogenu i bez nutnosti jeho růstu.
- Zkontrolujte kvalitu vzorku: Pokud byl vzorek moči nebo hlenu dopraven do laboratoře s velkým zpožděním, bakterie mohly uhynout nebo se rozmnožily jiné kontaminanty.
Správně provedené mikrobiologické vyšetření je nejlepším způsobem, jak se vyhnout hádání v medicíně a dostat přesně takou pomoc, jakou vaše tělo v daný moment potřebuje.